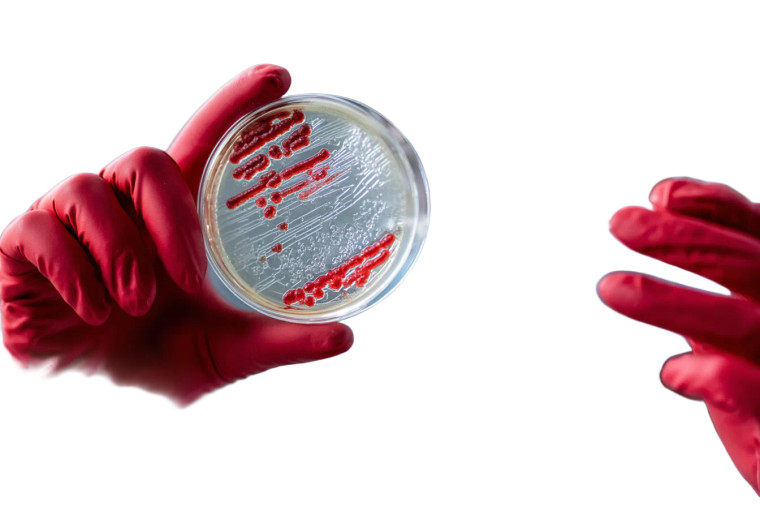
Scientist Examining Dish Vinyl Car Decal Sticker – Waterproof & UV-Resistant

Premium Waterproof Glossy Stickers
Durable • Weather-Resistant • Professional Quality
PROUDLY MADE IN CANADA
Key Features
Waterproof
Withstands all weather
UV Resistant
No fading in sunlight
Durable
3+ year outdoor life
Details
- Premium vinyl construction
- Professional-grade adhesive
- Indoor and outdoor use
- Scratch-resistant glossy finish
- Clean removal without residue
Specifications
- Origin: Made in Canada
- Material: Premium Vinyl
- Size: 5.75" inches
- Finish: Glossy
- Waterproof: Yes
Fast shipping • Satisfaction guaranteed